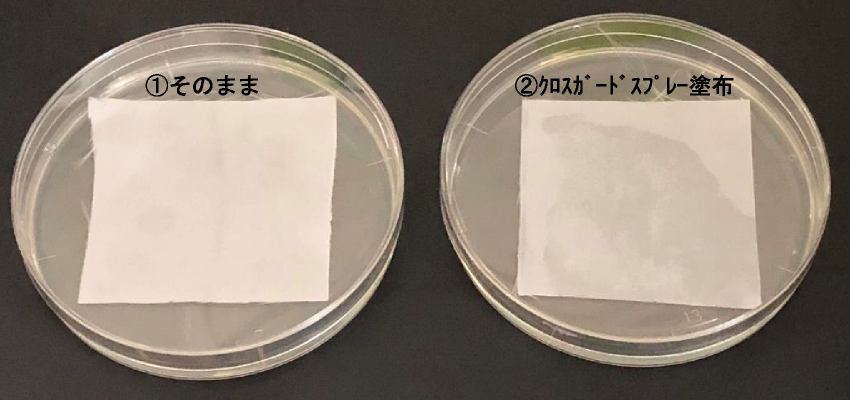
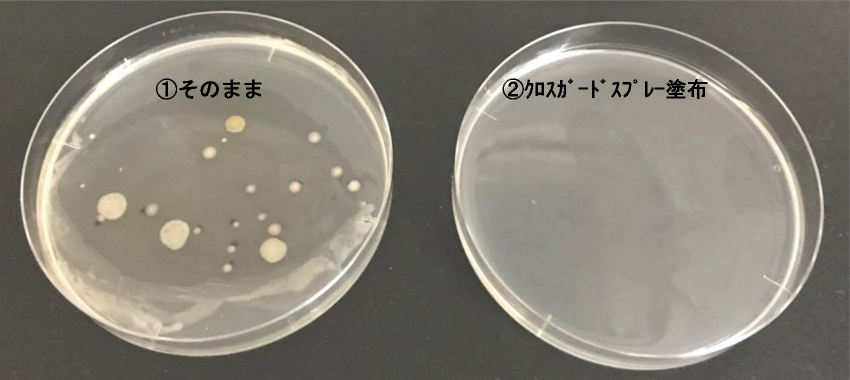

①シャンプー、霧吹きの水から守る
②パチパチ、まとわりつくの防ぐ
③繰り替え洗濯しても効果が持続するクロスの為のガードスプレー
| 成分 | アルコール、シリコーン樹脂、静電防止剤、香料、LPG |
|---|---|
| 液性 | 水に不溶 |
| 荷姿 | 280mlエアゾール缶 |
一般の静電気防止スプレー、
撥水スプレー ここが違う!
クロスガードスプレーの
機能メカニズム
クロスガードスプレー

撥水剤の中に静電防止剤を煉りこむ独自技術で、クロスガードスプレーは撥水と静電防止の相反する効果を両立させました。
撥水スプレー

静電防止スプレー

用途
シャンプークロス、カットクロス、エプロン、トリミングコートなどの撥水、静電防止、除菌
使用方法
①風通しのよい屋外でクロスから約20cm離して均一にスプレーして下さい。
クロスの外側面の必用部分にひと拭きで効果が得られます。
②1㎡に約10秒を目安に塗布して下さい。
③10分以上乾燥させてからご使用下さい
使用状の注意点
風通しのよい屋外でクロスから約20cm離して均一にスプレーして下さい。
クロスガードスプレー:Q&A
| Q | A | |
|---|---|---|
| 1 | 使用後の洗濯時に柔軟剤を入れて大丈夫ですか? | 大丈夫です。効果は変わりません。 |
| 2 | どの位塗布すれば良いですか? | 1平方mに約10秒を目安に塗布して下さい。 |
| 3 | 1本でどの位使用出来ますか? | 袖ありクロス全体に使用する場合は30秒塗布し1本で約15枚、袖なしクロスは20秒塗布し1本で約20枚、バックシャンプーは10秒塗布し1本で約40枚使用可能です。 |
| 4 | クロスの両面に塗布した方が良いですか? | 外面のみの塗布で大丈夫です。両面に塗布しても効果は変わりません。 |
| 5 | 洗濯すると効果は無くなりますか? | はっ水効果は洗濯20回、静電気防止効果は洗濯5回~15回効果が持続します。 |
| 6 | クロスの素材には影響ありませんか? | ナイロン・ポリエステル素材のクロスに影響はありません。ただし、極端に多く塗布すると成分が白く結晶化しますので、適量の塗布をお願いします。 |
| 7 | サロン内で使用しても大丈夫ですか? | クロスガードスプレーは家庭用防水スプレー製品同様に屋外での使用をお願いします。 |
| 8 | クロス以外で、使用してはいけないものはありますか? | 革製品・木材等シミになる恐れがあるもの、金属等腐食の心配があるものには使用しないで下さい。 |
| 9 | 除菌効果は十分ありますか?どの位持続しますか? | クロスガードスプレーは、はっ水剤と静電防止剤以外はエタノールと同等の除菌力があるIPAで構成されています。 IPAはエタノール同様、即効の除菌効果はありますが、揮発するため持続性はありません。 |
| 10 | どうしてはっ水と静電防止が両立できるのですか? | はっ水と静電防止を両立させる事は難しいと言われていますが、弊社技術で可能にしました。 |
| 11 | 使用後、皮膚には影響ないですか?アレルギーには大丈夫ですか? | クロスの外側面に噴霧し乾いてから使用下さい。肌に直接かけないようにして下さい。 |
| 12 | 連続で使用した時に、皮膜は厚くなりますか? | 重ね塗りすると被膜は厚くなりますが、効果が増大することはありません。 |
| 13 | 使用後、生地の通気性が悪くなりませんか? | クロスガードスプレーの被膜厚みは10ミクロン未満ですので、生地の通気性に影響を与えません。 |
| 14 | ネックシャッターに使用して、効果はありますか? | 静電防止効果(髪が付かない)があります。 |
| 15 | クロスガードスプレーを使用したのち、市販の除菌スプレーを使用しても大丈夫ですか? | 大丈夫です。市販の除菌スプレーで、撥水、静電防止効果を損なう事はありません。 |
| 16 | スタイリストさんの洋服に使用しても良いですか? | 大丈夫です。しかし、大量に使用すると、ムラになる可能性がありますので、適量の噴霧でお願いします。 |
| ①使用後の洗濯時に柔軟剤を入れて大丈夫ですか? |
|---|
| 大丈夫です。効果は変わりません。 |
| ②どの位塗布すれば良いですか? |
| 1平方mに約10秒を目安に塗布して下さい。 |
| ③1本でどの位使用出来ますか? |
| 袖ありクロス全体に使用する場合は30秒塗布し1本で約15枚、袖なしクロスは20秒塗布し1本で約20枚、バックシャンプーは10秒塗布し1本で約40枚使用可能です。 |
| ④クロスの両面に塗布した方が良いですか? |
| 外面のみの塗布で大丈夫です。両面に塗布しても効果は変わりません。 |
| ⑤洗濯すると効果は無くなりますか? |
| はっ水効果は洗濯20回、静電気防止効果は洗濯5回~15回効果が持続します。 |
| ⑥クロスの素材には影響ありませんか? |
| ナイロン・ポリエステル素材のクロスに影響はありません。ただし、極端に多く塗布すると成分が白く結晶化しますので、適量の塗布をお願いします。 |
| ⑦サロン内で使用しても大丈夫ですか? |
| クロスガードスプレーは家庭用防水スプレー製品同様に屋外での使用をお願いします。 |
| ⑧クロス以外で、使用してはいけないものはありますか? |
| 革製品・木材等シミになる恐れがあるもの、金属等腐食の心配があるものには使用しないで下さい。 |
| ⑨除菌効果は十分ありますか?どの位持続しますか? |
| クロスガードスプレーは、はっ水剤と静電防止剤以外はエタノールと同等の除菌力があるIPAで構成されています。 IPAはエタノール同様、即効の除菌効果はありますが、揮発するため持続性はありません。 |
| ⑩どうしてはっ水と静電防止が両立できるのですか? |
| はっ水と静電防止を両立させる事は難しいと言われていますが、弊社技術で可能にしました。 |
| ⑪使用後、皮膚には影響ないですか?アレルギーには大丈夫ですか? |
| クロスの外側面に噴霧し乾いてから使用下さい。肌に直接かけないようにして下さい。 |
| ⑫連続で使用した時に、皮膜は厚くなりますか? |
| 重ね塗りすると被膜は厚くなりますが、効果が増大することはありません。 |
| ⑬使用後、生地の通気性が悪くなりませんか? |
| クロスガードスプレーの被膜厚みは10ミクロン未満ですので、生地の通気性に影響を与えません。 |
| ⑭ネックシャッターに使用して、効果はありますか? |
| 静電防止効果(髪が付かない)があります。 |
| ⑮クロスガードスプレーを使用したのち、市販の除菌スプレーを使用しても大丈夫ですか? |
| 大丈夫です。市販の除菌スプレーで、撥水、静電防止効果を損なう事はありません。 |
| ⑯スタイリストさんの洋服に使用しても良いですか? |
| 大丈夫です。しかし、大量に使用すると、ムラになる可能性がありますので、適量の噴霧でお願いします。 |
クロスガードスプレーと他社品との違い
2ヶ月洗濯したクロス(長期使用)の撥水・防水・静電防止効果の違いを検証しました
<方法>
80回洗濯した静電防止加工クロス(カットクロス)と撥水加工クロス(シャンプークロス)に各スプレーを塗布して、撥水・防水・静電防止効果を確認しました。
撥水・防水性は蛇口の水をかけた状況を、静電防止効果は10回擦り合わせたクロスに髪の毛をのせて付着状況から表1の5段階にわけて評価しました。
試験は各2回反復をおこない、平均値を出しました。
表1 撥水・防水・静電防止効果の評価表
| -2 | -1 | 0 | 1 | 2 | |
|---|---|---|---|---|---|
| 撥水効果 | ![]() 撥水しない | ![]() 弱い撥水 | わずかに撥水 | ![]() 撥水する | ![]() 強い撥水 |
| 防水効果 | ![]() 防水しない | ![]() 弱い防水 | わずかに防水 | ![]() 防水する | ![]() 強い防水 |
| 静電防止効果 | ![]() はたいてもほとんど残る | ![]() はたいて少し残る | 何回か はたくと 取れる | 一回はたくと 取れる | ![]() 付着しない |
| 撥水効果 | |
|---|---|
| -2 | ![]() 撥水しない |
| -1 | ![]() 弱い撥水 |
| 0 | わずかに撥水 |
| 1 | ![]() 撥水する |
| 2 | ![]() 強い撥水 |
| 防水効果 | |
| -2 | ![]() 防水しない |
| -1 | ![]() 弱い防水 |
| 0 | わずかに防水 |
| 1 | ![]() 防水する |
| 2 | ![]() 強い防水 |
| 静電防止効果 | |
| -2 | ![]() はたいてもほとんど残る |
| -1 | ![]() はたいて少し残る |
| 0 | 何回かはたくと取れる |
| 1 | 一回はたくと取れる |
| 2 | ![]() 付着しない |
何も塗布していない(無塗布)の新品クロスと80回洗濯後クロスでも同様の試験をおこないました。
<結果>
試験結果を表2に示します。
表2 クロスの撥水・防水・静電防止効果



80回洗濯することにより、カットクロスの撥水・防水・静電防止効果が低下し、シャンプークロスの防水効果が低下しました。
市販防水スプレー塗布により、カットクロスの撥水効果と防水効果が復活しました。
市販静電防止スプレー塗布により、カットクロスの静電防止効果が復活し、シャンプークロスの静電防止効果が向上しました。また、市販静電防止スプレー塗布により、カットクロスの撥水・防水効果の低下が見られました。
クロスガードスプレー塗布により、市販防水スプレー同等の撥水・防水効果と市販静電防止スプレー以上の静電防止効果が見られました。
クロスガードスプレーは、市販防水スプレーの撥水・防水効果と市販静電防止スプレーの静電防止効果を併せ持っていると考えられます。
【使用事例】
シャンプークロス、カットクロス、ネックシャッターに使用
(1)クロスを洗濯することによる撥水・防水・静電防止効果の経時変化(塗布寿命調査)
<方法>
クロスガードスプレー、市販防水スプレーと市販静電防止スプレーを塗布したカットクロスとシャンプークロスを20回洗濯しながら、撥水・防水・静電防止効果の経時変化を観察しました。
撥水・防水性は蛇口の水をかけた状況を、静電防止効果は10回擦り合わせたクロスに髪の毛をのせて付着状況から表1の5段階にわけて評価しました。
試験は各3回反復をおこない、平均値を出しました。
表1 撥水・防水・静電防止効果の評価表
| -2 | -1 | 0 | 1 | 2 | |
|---|---|---|---|---|---|
| 撥水効果 | ![]() 撥水しない | ![]() 弱い撥水 | わずかに撥水 | ![]() 撥水する | ![]() 強い撥水 |
| 防水効果 | ![]() 防水しない | ![]() 弱い防水 | わずかに防水 | ![]() 防水する | ![]() 強い防水 |
| 静電防止効果 | ![]() はたいてもほとんど残る | ![]() はたいて少し残る | 何回か はたくと 取れる | 一回はたくと 取れる | ![]() 付着しない |
| 撥水効果 | |
|---|---|
| -2 | ![]() 撥水しない |
| -1 | ![]() 弱い撥水 |
| 0 | わずかに撥水 |
| 1 | ![]() 撥水する |
| 2 | ![]() 強い撥水 |
| 防水効果 | |
| -2 | ![]() 防水しない |
| -1 | ![]() 弱い防水 |
| 0 | わずかに防水 |
| 1 | ![]() 防水する |
| 2 | ![]() 強い防水 |
| 静電防止効果 | |
| -2 | ![]() はたいてもほとんど残る |
| -1 | ![]() はたいて少し残る |
| 0 | 何回かはたくと取れる |
| 1 | 一回はたくと取れる |
| 2 | ![]() 付着しない |
何も塗布していないクロス(無処理)も同様の試験をおこないました。
<結果>
試験結果を表3に示します。
表3 クロスの撥水・防水・静電防止効果の経時変化
カットクロス



シャンプークロス



カットクロス



シャンプークロス



無処理のカットクロスの撥水・防水効果は洗濯20回前に、静電防止効果は洗濯5回前に評価点数0以下になりました。その中でクロスガードスプレーを塗布したクロスが洗濯20回後の撥水・防水・静電防止効果全てで最も良い評価点数を得ましたが、静電防止効果は洗濯20回前に評価点数0以下になりました。
シャンプークロスの撥水・防水効果は洗濯20回後どれも高い評価点数を得ました。静電防止効果はクロスガードスプレーが最も良い評価点数を得ましたが、洗濯10回前に評価点数0以下になりました。
市販静電防止スプレーは洗濯2回で洗い流され静電防止効果を発揮しませんでした。
特に静電防止効果でクロスガードスプレーが高い持続性を示しました。
(2)除菌効果についてテストしました
<方法>
使い古したスポンジを握った手で触ったクロスを①そのまま ②クロスガードスプレーを塗布後生菌数測定寒天培地上に載せ、29℃の培養器に3日間入れて菌が発生するか確認しました。
<結果>
①そのままのクロスで菌の発生が見られましたが、②クロスガードスプレーを塗布したクロスで菌の発生は見られませんでした。
クロスガードスプレーの除菌力が確認されました。
(3)花粉の時期必見! 花粉の落ちやすさテスト
<方法>
2種類のナイロンクロス生地でクロスガードスプレー塗布・無塗布の試験をおこないました。

<結果>
試験結果の写真を下記に示します。
左:クロスガード塗布
右:無塗布

クロスガードスプレーの撥水・静電防止効果により、クロスに付着した花粉が落ちやすくなる事が確認されました。
(4)ネックシャッターへの静電防止効果
<方法>
左半分にクロスガードを塗布、右半分は無塗布のネックシャッターを塩ビ棒でこすり、静電気を発生させてから髪の毛をのせ、はたいた後の髪の毛の残り具合を観察しました。
<結果>
試験結果の写真を下記に示します。

クロスガードスプレーの静電防止効果により、ネックシャッターに髪の毛が付着しにくい事が確認されました。










